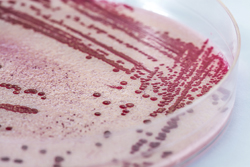

Neuer Biosensor für Nahrungsmittelpathogene
Viren, Bakterien und Pilze in Lebensmitteln sind für Krankheiten, Todesfälle und massive wirtschaftliche Verluste verantwortlich. Mit neuen molekularbiologischen Methoden können nun Kontaminanten in Lebensmitteln schneller und einfacher identifiziert werden.Das EU-finanzierte Projekt PATHFINDER (Rapid and reliable detection of foodborne pathogens by employing multiplexing biosensor technology) sollte einen Biosensor entwickeln, der gleichzeitig mehrere krankheitserregende Bakterien nachweist.PATHFINDER generierte und erfasste eine Reihe von Molekülen, die Nahrungsmittelpathogene binden können. Hergestellt wurden Antikörper gegen Listeria monocytogenes, Campylobacter jejuni und Campylobacter coli, weiterhin wurden Molekülbibliotheken nach Substanzen durchsucht, die Salmonellen binden.Ein weiterer Schwerpunkt war der Test von Biosensormethoden. Ein SPR-Biosensor (Oberflächen-Plasmonen-Resonanz) ist empfindlicher als herkömmliche Labornachweisverfahren, versagte im Test allerdings bei C.jejuni. MAGPIX, ein weiterer Sensor, war erfolgreicher und wurde ins Protokoll von PATHFINDER integriert, um L.monocytogenes C.jejuni und Salmonella sp.gleichzeitig zu erkennen. In der nächsten Projektphase wird das von MAGPIX entwickelte Biosensorprotokoll an kommerziellen Lebensmittelproben getestet. PATHFINDER vereinfachte damit den Nachweis von Lebensmittelkontaminanten, indem es neue molekulare Substanzen für die Bindung wie auch neue Nachweismethoden entwickelte.